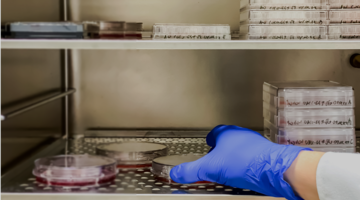

Medizin & Gesundheitstechnik
Intelligente RFID-Lösungen
Unsere RFID-Technologie ermöglicht eine lückenlose Identifikation, Nachverfolgung und Zustandsüberwachung medizinischer Instrumente, Proben und Sterilisationsprozesse. Ob in der Chirurgie, der Labordiagnostik oder der Prozessdokumentation – unsere Lösungen steigern Effizienz, Sicherheit und Rückverfolgbarkeit.
Entdecken Sie hier unsere Lösungen im Detail – präzise, zuverlässig und bereit für Ihre Anwendung im Gesundheitswesen.
Zubehöridentifikation
RFID-Lösungen für chirurgische Instrumente – robust, präzise und rückverfolgbar

Unsere RFID-Systeme ermöglichen die sichere Identifikation, Dokumentation und Rückverfolgbarkeit von medizinischem Zubehör – speziell auch von chirurgischen Instrumenten. Dank miniaturisierter, hitze- und druckbeständiger TAGs bleiben Funktion und Sterilisation vollständig erhalten.
Highlights unserer RFID-Lösung:
Identifikation von Sterilisationsbehältern
Sichere Identifikation und Rückverfolgbarkeit im Sterilisationsprozess

Unsere RFID-Lösungen bieten eine robuste und langlebige Möglichkeit, Sterilisationsbehälter zuverlässig zu kennzeichnen und in digitale Prozesse zu integrieren – auch bei extremen Bedingungen.
Highlights unserer RFID-Lösung:
Prozessüberwachung
Zuverlässige Kontrolle kritischer Parameter – drahtlos und in Echtzeit
Für hygienerelevante und sicherheitskritische Prozesse ist eine kontinuierliche Überwachung unerlässlich. Unsere RFID-gestützten Systeme liefern präzise Messdaten direkt aus dem Prozess – auch unter härtesten Bedingungen.
Highlights unserer RFID-Lösung:
Mit jahrzehntelanger Erfahrung in der RFID-Entwicklung bietet microsensys ein umfangreiches Portfolio an speziell für den medizinischen Bereich optimierten Produkten. Ob miniaturisierte Transponder für chirurgische Instrumente, robuste TAGs für Sterilisationsbehälter oder intelligente Sensorlösungen zur Prozessüberwachung – unsere Technologien sind auf höchste Ansprüche in Hygiene, Sicherheit und Rückverfolgbarkeit ausgelegt.
Weiterführende Informationen